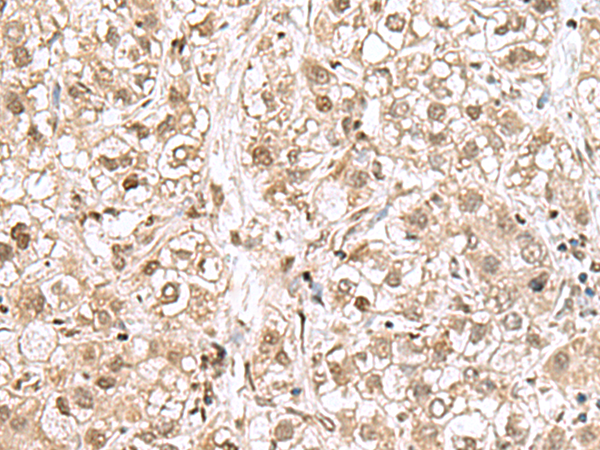

-
分类: 科研抗体货号: P10250别名: EIF1A; EIF4C; eIF-1A; eIF-4C; EIF1AP1应用: IHC反应种属: Human, Mouse
-
分类: 科研抗体货号: P10234别名: L35应用: WB,IHC反应种属: Human, Mouse, Rat
-
分类: 科研抗体货号: P10244别名: CD-RAP应用: IHC反应种属: Human, Mouse, Rat
-
分类: 科研抗体货号: P10249别名: L31MT; L42MT; S32MT; MRPL31; MRPS32; PTD007; RPML31; HSPC204; MRP-L31; MRP-L42; MRP-S32应用: WB,IHC反应种属: Human, Rat
-
分类: 科研抗体货号: P10260别名:应用: WB,IHC反应种属: Human, Mouse
-
分类: 科研抗体货号: P10243别名: Soh1; CGI-125; 3110004H13Rik应用: IHC反应种属: Human, Mouse
-
分类: 科研抗体货号: P10248别名: HBZ1; HBZ-T1应用: WB,IHC反应种属: Human
-
分类: 科研抗体货号: P10258别名: RAC1; RIB1; RNS1应用: WB,IHC反应种属: Human, Mouse, Rat
-
分类: 科研抗体货号: P10242别名: HITS; C10orf45应用: IHC反应种属: Human, Mouse, Rat
-
分类: 科研抗体货号: P10247别名: TAFA-4; FAM19A4应用: WB,IHC反应种属: Human, Mouse, Rat

鄂公网安备42018502007531号
鄂公网安备42018502007531号

